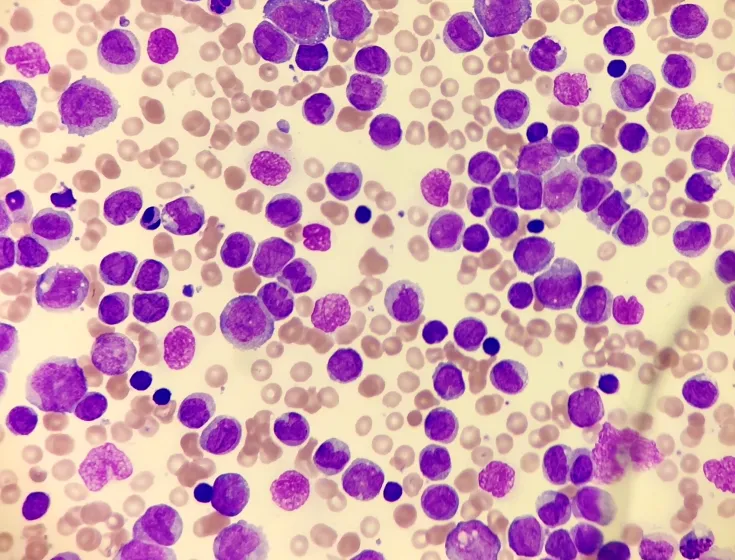
oryzon pic

Search
Sumario de resultados
TIpos de contenido
Fecha
-
-
 New
New#NewMember | "We consider it a priority to be part of AseBio. It is a key driver of biotec...
Meet the Centre for Plant Biotechnology and Genomics (CBGP, UPM-INIA/CSIC), our new member. We spoke to Antonio Molina, director of the entity
-
 Event
EventGenesis Conference
-
 Event
EventBioFIT 2022
-
New
NewORYZON announces FDA approval of IND for FRIDA, a Phase Ib trial with iadademstat in R/R A...
In combination with gilteritinib Primary objectives: to assess safety, tolerability and RP2D Secondary objectives: to assess efficacy
-
 Event
EventMEDICA
-
-
-
 Event
EventCPHI Worldwide (Europe)
-
 Event
EventBIO-Europe
-
 Event
EventBIOJAPAN 2022
-
-
-
 Company
CompanyMikrobiomik
-
-
 Event
EventBiopharm America
-
 Event
EventBIO IMPACT
-
 Event
EventMedFit
-
 New
NewIllumina Accelerator Startup Funding
About Illumina for Startups At Illumina, we’re committed to unlocking the power of the genome, and we know we can’t do it alone.
-
 Press release
Press releaseAseBio, RAICEX, Farmaindustria and Fenin launch a study to better attract international ta...
Over 80% of Spanish scientists abroad surveyed would like to return to Spain, but only 24% really know about the opportunities available. Offering attractive career prospects and competitive financial
-
 Press release
Press releaseGrowing number of women in R&D at biotech companies
Women make up 58% of all R&D staff, but hold only 24.4% of executive positions in the biotech sector






